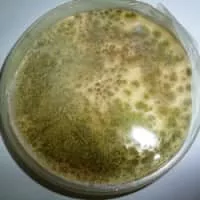
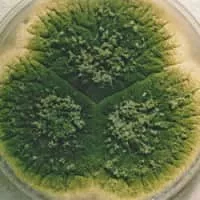
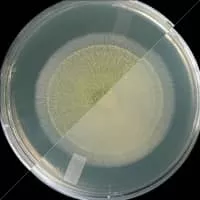

Aspergillus Flavus
| Use attributes for filter ! | |
| Kingdom | Fungi |
|---|---|
| Scientific name | Aspergillus flavus |
| Class | Eurotiomycetes |
| Order | Eurotiales |
| Rank | Species |
| Did you know | To ensure grains and legumes remain free of A. flavus infection, certain conditions must be incorporated before, during, and after harvest. |
| Date of Reg. | |
| Date of Upd. | |
| ID | 952016 |
About Aspergillus Flavus
Aspergillus flavus is a saprotrophic and pathogenic fungus with a cosmopolitan distribution. It is best known for its colonization of cereal grains, legumes, and tree nuts. Postharvest rot typically develops during harvest, storage, and/or transit.